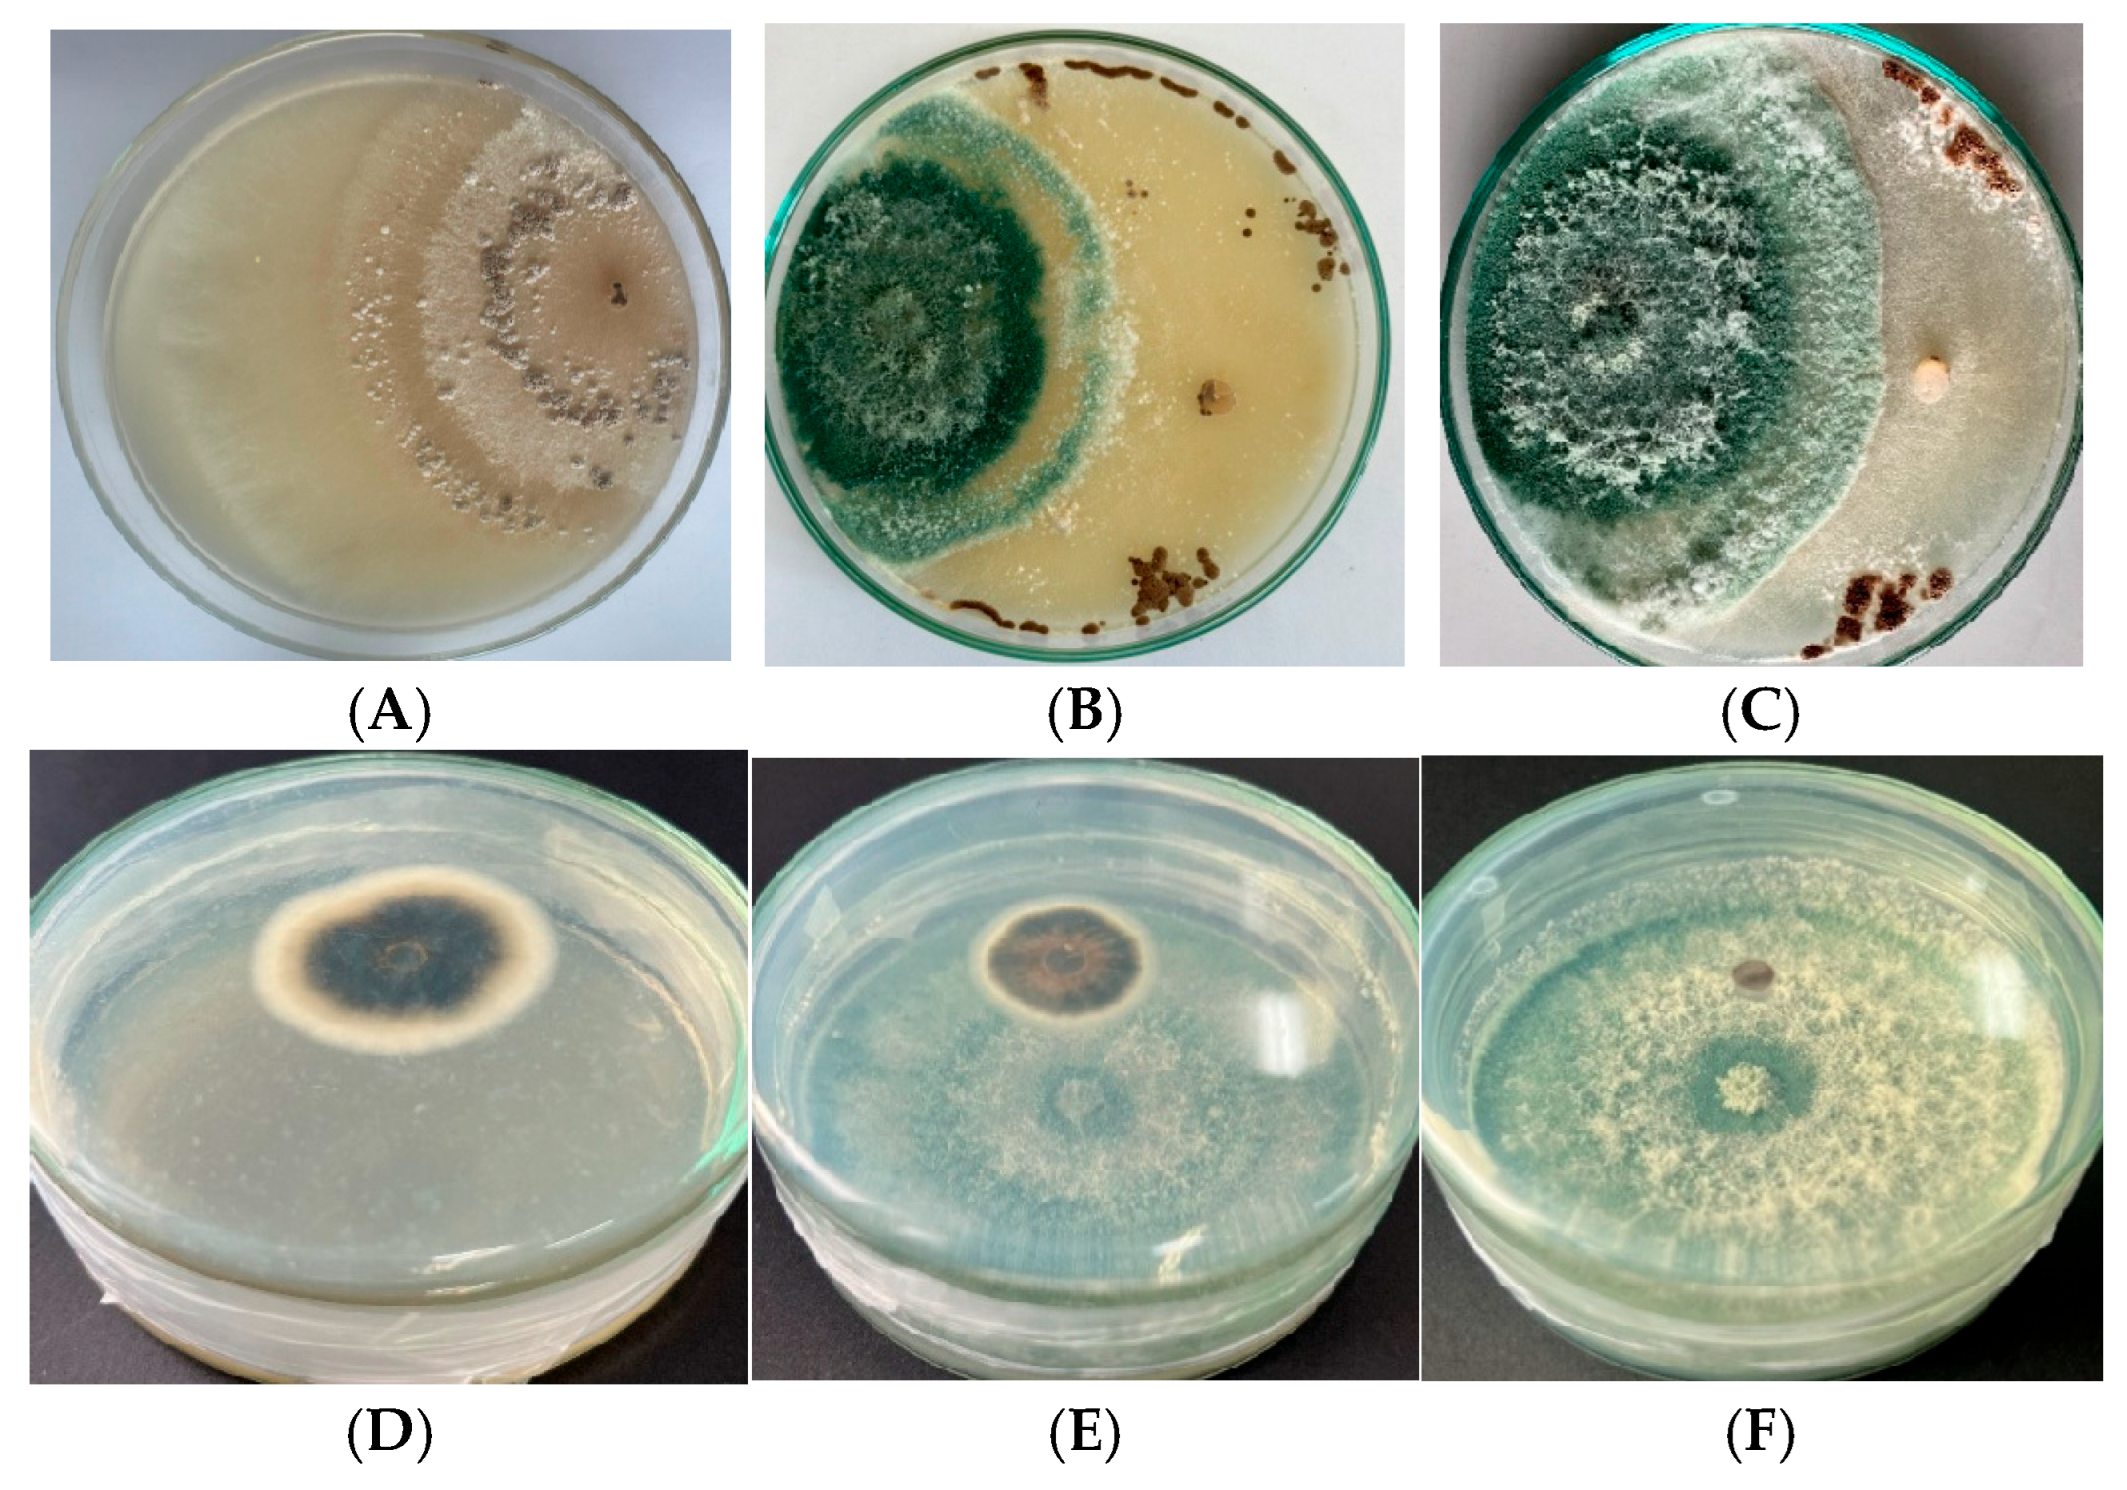
Applbiosci 04 00041 g004 Applbiosci 04 00041 g004

Gamma Irradiation Enhances the In Vitro Biocontrol Potential of Trichoderma Species Against Major Rice Pathogens Rhizoctonia solani and Pyricularia oryzae
Abstract
1. Introduction
2. Materials and Methods
2.1. Materials
2.2. Methods
2.2.1. Classification of the Trichoderma Strains
2.2.2. Gamma Irradiation and Spore Survivability
2.2.3. Screening and Selection of Mutants
- Inhibition via cellophane membrane (ICM) was applied to assess the effect of non-volatile metabolites diffused through a sterile cellophane membrane on PDA medium as described by a previous study [29].
- Inhibition via dual culture (IDC) was used to evaluate direct antagonism and spatial competition with R. solani on shared PDA plates.
- Inhibition via volatile organic compounds (IVOCs) tested the effect of VOCs produced from the mutants against P. oryzae using a sealed sandwich plate system.
- −
- I is the inhibition rate (%), designated as ICM, IDC, or IVOCs;
- −
- DT is the colony diameter (mm) in the treatment group;
- −
- DC is the colony diameter (mm) in the control group.
- Cellophane Membrane Assay (ICM)
- Dual Culture Assay (IDC)
- Sandwich Plate Assay (IVOCs)
2.2.4. Chitinase Activity Assay
2.2.5. Investigation of Genetic Changes by Randomly Amplified Polymorphic DNA (RAPD) Analysis
2.2.6. Statistical Analysis
3. Results
3.1. Classification of Trichoderma Strains
3.2. Effects of Gamma Irradiation on Spore Survival Rate of Trichoderma
3.3. Potential Mutants with High Antagonistic Activity Against R. solani and P. oryzae
3.3.1. Antifungal Activity
3.3.2. Chitinase Activity
3.3.3. Investigation of the Genetic Changes by RAPD
4. Discussion
5. Conclusions
Author Contributions
Funding
Institutional Review Board Statement
Informed Consent Statement
Data Availability Statement
Acknowledgments
Conflicts of Interest
Correction Statement
References
- Bin Rahman, A.N.M.R.; Zhang, J. Trends in Rice Research: 2030 and Beyond. Food Energy Secur. 2023, 12, e390. [Google Scholar] [CrossRef]
- Peng, S.; Huang, J.; Sheehy, J.E.; Laza, R.C.; Visperas, R.M.; Zhong, X.; Centeno, G.S.; Khush, G.S.; Cassman, K.G. Rice Yields Decline with Higher Night Temperature from Global Warming. Proc. Natl. Acad. Sci. USA 2004, 101, 9971–9975. [Google Scholar] [CrossRef] [PubMed]
- Wassmann, R.; Jagadish, S.V.K.; Heuer, S.; Ismail, A.; Redona, E.; Serraj, R.; Singh, R.K.; Howell, G.; Pathak, H.; Sumfleth, K. Chapter 2 Climate Change Affecting Rice Production: The Physiological and Agronomic Basis for Possible Adaptation Strategies. In Advances in Agronomy; Sparks, D.L., Ed.; Academic Press: Cambridge, MA, USA, 2009; Volume 101, pp. 59–122. [Google Scholar]
- Persaud, R.; McGowan, D.; Persaud, M. Managing the Imminent Danger of Rice Blast (Pyricularia oryzae Cav.) and Sheath Blight (Rhizoctonia Solani Kühn) Disease: A Critical Review Article. Am. J. Agric. For. 2021, 9, 409–423. [Google Scholar] [CrossRef]
- Savary, S.; Willocquet, L.; Elazegui, F.A.; Castilla, N.P.; Teng, P.S. Rice Pest Constraints in Tropical Asia: Quantification of Yield Losses Due to Rice Pests in a Range of Production Situations. Plant Dis. 2000, 84, 357–369. [Google Scholar] [CrossRef]
- Asibi, A.E.; Chai, Q.; Coulter, J.A. Rice Blast: A Disease with Implications for Global Food Security. Agronomy 2019, 9, 451. [Google Scholar] [CrossRef]
- Phi, A. (Helen) Current Status of Rice Blast in Vietnam and Future Perspectives. Open Access Libr. J. 2023, 10, e10636. [Google Scholar] [CrossRef]
- Aktar, M.W.; Sengupta, D.; Chowdhury, A. Impact of Pesticides Use in Agriculture: Their Benefits and Hazards. Interdiscip. Toxicol. 2009, 2, 1–12. [Google Scholar] [CrossRef]
- Tilman, D.; Cassman, K.G.; Matson, P.A.; Naylor, R.; Polasky, S. Agricultural Sustainability and Intensive Production Practices. Nature 2002, 418, 671–677. [Google Scholar] [CrossRef]
- Berg, G. Plant-Microbe Interactions Promoting Plant Growth and Health: Perspectives for Controlled Use of Microorganisms in Agriculture. Appl. Microbiol. Biotechnol. 2009, 84, 11–18. [Google Scholar] [CrossRef]
- Shoresh, M.; Harman, G.E.; Mastouri, F. Induced Systemic Resistance and Plant Responses to Fungal Biocontrol Agents. Annu. Rev. Phytopathol. 2010, 48, 21–43. [Google Scholar] [CrossRef]
- Vinale, F.; Sivasithamparam, K.; Ghisalberti, E.L.; Marra, R.; Woo, S.L.; Lorito, M. Trichoderma–Plant–Pathogen Interactions. Soil Biol. Biochem. 2008, 40, 1–10. [Google Scholar] [CrossRef]
- Benítez, T.; Rincón, A.M.; Limón, M.C.; Codón, A.C. Biocontrol Mechanisms of Trichoderma Strains. Int. Microbiol. Off. J. Span. Soc. Microbiol. 2004, 7, 249–260. [Google Scholar]
- Schuster, A.; Schmoll, M. Biology and Biotechnology of Trichoderma. Appl. Microbiol. Biotechnol. 2010, 87, 787–799. [Google Scholar] [CrossRef]
- Harman, G.E.; Howell, C.R.; Viterbo, A.; Chet, I.; Lorito, M. Trichoderma Species—Opportunistic, Avirulent Plant Symbionts. Nat. Rev. Microbiol. 2004, 2, 43–56. [Google Scholar] [CrossRef] [PubMed]
- Lorito, M.; Woo, S.L.; Harman, G.E.; Monte, E. Translational Research on Trichoderma: From ’omics to the Field. Annu. Rev. Phytopathol. 2010, 48, 395–417. [Google Scholar] [CrossRef]
- Steyaert, J.M.; Weld, R.J.; Mendoza-Mendoza, A.; Stewart, A. Reproduction without Sex: Conidiation in the Filamentous Fungus Trichoderma. Microbiol. Read. Engl. 2010, 156, 2887–2900. [Google Scholar] [CrossRef]
- Nguyen, D.H.; Pham, Q.N.; Nguyen, T.T.H.; Ha, G.; Nguyen, V.V.; Nguyen, T.C. Isolation and Evaluation of the Antagonistic Ability of Trichoderma asperllum against Soilborne Pathogens. Vietnam J. Agric. Sci. 2017, 15, 1593–1604. [Google Scholar]
- Nguyen, T.D.; Nguyen, T.T.; Cao, T.T.D.; Quach, T.H.; Nguyen, T.M.T.; Pham, K.P.; Nguyen, T.T.H.; Phan, L.N.; Tran, P.T.; Truong, T.O.; et al. Study on the production technique of Trichoderma formulation for controlling citrus yellow leaf and root rot disease. Vietnam J. Sci. Technol. 2022, 64, 60–64. [Google Scholar] [CrossRef]
- Kiefer, J. Radiation Induced Mutations. In Fundamentals for the Assessment of Risks from Environmental Radiation; Baumstark-Khan, C., Kozubek, S., Horneck, G., Eds.; Springer: Dordrecht, The Netherlands, 1999; pp. 269–280. ISBN 978-94-011-4585-5. [Google Scholar]
- Youk, J.; Kwon, H.W.; Lim, J.; Kim, E.; Kim, T.; Kim, R.; Park, S.; Yi, K.; Nam, C.H.; Jeon, S.; et al. Quantitative and Qualitative Mutational Impact of Ionizing Radiation on Normal Cells. Cell Genom. 2024, 4, 100499. [Google Scholar] [CrossRef]
- Haggag, W.M.; Mohamed, H.A.A. Enhanecment of Antifungal Metabolite Production from Gamma-Ray Induced Mutants of Some Trichoderma Species for Control Onion White Disease. Plant Pathol. Bull. 2022, 11, 45–56. [Google Scholar]
- Abbasi, S.; Safaie, N.; Shams-bakhsh, M.; Shahbazi, S. Biocontrol Activities of Gamma Induced Mutants of Trichoderma harzianum against Some Soilborne Fungal Pathogens and Their DNA Fingerprinting. Iran. J. Biotechnol. 2016, 14, 260–269. [Google Scholar] [CrossRef]
- Ghasemi, S.; Safaie, N.; Shahbazi, S.; Shams-Bakhsh, M.; Askari, H. Enhancement of Lytic Enzymes Activity and Antagonistic Traits of Trichoderma harzianum Using γ-Radiation Induced Mutation. J. Agric. Sci. Technol. 2019, 21, 1035–1048. [Google Scholar]
- Soufi, E.; Safaie, N.; Shahbazi, S.; Mojerlou, S. Gamma Irradiation Induces Genetic Variation and Boosting Antagonism in Trichoderma aureoviride. Arch. Phytopathol. Plant Prot. 2021, 54, 1649–1674. [Google Scholar] [CrossRef]
- Haque, Z.; Iqbal, M.S.; Ahmad, A.; Khan, M.S.; Prakash, J. Molecular Characterization of Trichoderma spp. Isolates by Internal Transcribed Spacer (ITS) Region Sequencing Technique and Its Use as a Biocontrol Agent. Open Biotechnol. J. 2020, 14, 70–77. [Google Scholar] [CrossRef]
- Darabzadeh, N.; Hamidi-Esfahani, Z.; Hejazi, P. Optimization of Cellulase Production under Solid-state Fermentation by a New Mutant Strain of Trichoderma reesei. Food Sci. Nutr. 2018, 7, 572–578. [Google Scholar] [CrossRef]
- Diep, T.B.; Thom, N.T.; Sang, H.D.; An, T.X.; Binh, N.V.; Quynh, T.M. Effect of Gamma Irradiation on the Viability and Cellulase Production of Some Filamentous Fungi. Vietnam J. Biotechnol. 2020, 18, 341–348. [Google Scholar] [CrossRef]
- Liu, S.-Y.; Feng, P.-C.; Lo, C.-T.; Peng, K.-C. Plate Assay for Fungal Enzymes Using Cellophane Membranes. Anal. Biochem. 2010, 397, 121–123. [Google Scholar] [CrossRef]
- Alfiky, A. Effects of Ultraviolet Irradiation on the in Vitro Antagonistic Potential of Trichoderma spp. against Soil-Borne Fungal Pathogens. Heliyon 2019, 5, e02111. [Google Scholar] [CrossRef]
- Mukhammadiev, R.; Mukhammadiev, R.; Skvortsov, E.; Cheremisin, A.; Zavriev, S.; Gerner, A.; Valiullin, L. Chitinase Production by Trichoderma viride in Submerged State Fermentation. IOP Conf. Ser. Earth Environ. Sci. 2020, 578, 012009. [Google Scholar] [CrossRef]
- Schlick, A.; Kuhls, K.; Meyer, W.; Lieckfeldt, E.; Börner, T.; Messner, K. Fingerprinting Reveals Gamma-Ray Induced Mutations in Fungal DNA: Implications for Identification of Patent Strains of Trichoderma harzianum. Curr. Genet. 1994, 26, 74–78. [Google Scholar] [CrossRef]
- Nguyen, T.Q.; Dao, T.K.; Nguyen, H.D.; Phung, T.B.T.; Pham, T.T.N.; Nguyen, T.V.H.; Trinh, T.H.; Le, H.C.; Le, T.T.H.; Do, T.H. Application of PCR-Based Techniques for the Identification of Genetic Fingerprint Diversity of Dominant Bacteria in Fecal Samples of Children with Diarrhea in Vietnam. Infect. Dis. Rep. 2024, 16, 932–951. [Google Scholar] [CrossRef] [PubMed]
- Kubiak, A.; Wolna-Maruwka, A.; Pilarska, A.A.; Niewiadomska, A.; Piotrowska-Cyplik, A. Fungi of the Trichoderma Genus: Future Perspectives of Benefits in Sustainable Agriculture. Appl. Sci. 2023, 13, 6434. [Google Scholar] [CrossRef]
- Rostami, M.; Ghorbani, A.; Shahbazi, S. Gamma Radiation-Induced Enhancement of Biocontrol Agents for Plant Disease Management. Curr. Res. Microb. Sci. 2024, 7, 100308. [Google Scholar] [CrossRef]
- Baharvand, A.; Shahbazi, S.; Afsharmanesh, H. Ali Investigation of Gamma Irradiation on Morphological Characteristics and Antagonist Potential of Trichoderma viride against M. Phaseolina. Int. J. Farming Allied Sci. 2014, 3, 1157–1164. [Google Scholar]
- Abd Alla El-Bialy, H.; Adel-Fattah Mohamed Shahin, A.; El-Fouly, M.Z.; Awad, M.A.; Khalifa, E.-S.Z.; Fahmy, S.M. Volatiles and Functional Peptides Compositions of Trichoderma Variants Induced by a New Strategy of Irradiation. Biocatal. Agric. Biotechnol. 2019, 20, 101261. [Google Scholar] [CrossRef]
- Wagh, S.; Ingle, S.T.; Dandale, S.; Mane, S.S. Improvement in Biocontrol Ability of Trichoderma viride through Gamma Irradiation. Trends Biosci. 2015, 8, 5622–5626. [Google Scholar]
- Fernandez, J.; Orth, K. Rise of a Cereal Killer: The Biology of Magnaporthe Oryzae Biotrophic Growth. Trends Microbiol. 2018, 26, 582–597. [Google Scholar] [CrossRef] [PubMed]
- Kong, H.; Hong, X.; Li, X. Current Perspectivesin Pathogenesis and Antimicrobial Resistance of Enteroaggregative Escherichia coli. Microb. Pathog. 2015, 85, 44–49. [Google Scholar] [CrossRef] [PubMed]

| Fungal Strain/Potential Mutant | ICM (%) | IDC (%) | IVOCs(%) | |
|---|---|---|---|---|
| R. solani | P. oryzae | R. solani | P. oryzae | |
| Trichoderma sp. TVN-A0 | 61.43 a ± 0.84 | 54.73 a ± 1.63 | 57.71 a ± 1.19 | 55.62 a ± 1.59 |
| AM1 | 90.63 d ± 1.21 | 75.38 c ± 1.47 | 80.75 e ± 1.88 | 81.10 c ± 0.66 |
| AM2 | 96.71 e ± 0.97 | 92.57 d ± 1.06 | 87.76 g ± 1.29 | 83.57 d ± 1.15 |
| AM3 | 81.91 b ± 1.28 | 71.43 b ± 1.36 | 67.58 b ± 1.72 | 73.39 b ± 0.83 |
| AM4 | 85.26 c ± 1.40 | 70.85 b ± 1.89 | 74.38 d ± 0.64 | 75.49 b ± 1.31 |
| AM5 | 87.26 c ± 0.33 | 69.25 b ± 0.52 | 71.67 c ± 1.30 | 73.36 b ± 1.62 |
| Trichoderma sp. TVN-H0 | 63.25 a ± 0.54 | 56.43 a ± 1.23 | 60.26 a ± 0.68 | 58.82 a ± 0.48 |
| HM1 | 100.00 e ± 0.00 | 74.75 b ± 1.39 | 68.67 b ± 1.21 | 78.42 d ± 1.25 |
| HM2 | 95.33 d ± 0.51 | 85.28 d ± 1.24 | 91.24 e ± 1.22 | 79.33 d ± 0.44 |
| HM3 | 93.26 c ± 1.04 | 83.51 d ± 0.98 | 75.41 c ± 1.46 | 69.29 b ± 0.70 |
| HM4 | 95.06 d ± 1.37 | 77.65 c ± 0.91 | 84.54 d ± 1.79 | 71.57 c ± 0.54 |
| HM5 | 86.73 b ± 0.95 | 73.24 b ± 0.58 | 83.39 d ± 0.68 | 67.79 b ± 0.63 |
Disclaimer/Publisher’s Note: The statements, opinions and data contained in all publications are solely those of the individual author(s) and contributor(s) and not of MDPI and/or the editor(s). MDPI and/or the editor(s) disclaim responsibility for any injury to people or property resulting from any ideas, methods, instructions or products referred to in the content. |
© 2025 by the authors. Licensee MDPI, Basel, Switzerland. This article is an open access article distributed under the terms and conditions of the Creative Commons Attribution (CC BY) license (https://creativecommons.org/licenses/by/4.0/).
Share and Cite
Tran, B.D.; Tran, H.T.; Hoang, D.S.; Tran, H.N.; Dao, N.K.L.; Le, X.V.; Tran, X.A.; Nguyen, H.D.; Le, T.T.H.; Do, T.H. Gamma Irradiation Enhances the In Vitro Biocontrol Potential of Trichoderma Species Against Major Rice Pathogens Rhizoctonia solani and Pyricularia oryzae. Appl. Biosci. 2025, 4, 41. https://doi.org/10.3390/applbiosci4030041
Tran BD, Tran HT, Hoang DS, Tran HN, Dao NKL, Le XV, Tran XA, Nguyen HD, Le TTH, Do TH. Gamma Irradiation Enhances the In Vitro Biocontrol Potential of Trichoderma Species Against Major Rice Pathogens Rhizoctonia solani and Pyricularia oryzae. Applied Biosciences. 2025; 4(3):41. https://doi.org/10.3390/applbiosci4030041
Chicago/Turabian StyleTran, Bang Diep, Huyen Thanh Tran, Dang Sang Hoang, Hong Nhung Tran, Ngoc Khanh Linh Dao, Xuan Vinh Le, Xuan An Tran, Hong Duong Nguyen, Thi Thu Hong Le, and Thi Huyen Do. 2025. "Gamma Irradiation Enhances the In Vitro Biocontrol Potential of Trichoderma Species Against Major Rice Pathogens Rhizoctonia solani and Pyricularia oryzae" Applied Biosciences 4, no. 3: 41. https://doi.org/10.3390/applbiosci4030041
APA StyleTran, B. D., Tran, H. T., Hoang, D. S., Tran, H. N., Dao, N. K. L., Le, X. V., Tran, X. A., Nguyen, H. D., Le, T. T. H., & Do, T. H. (2025). Gamma Irradiation Enhances the In Vitro Biocontrol Potential of Trichoderma Species Against Major Rice Pathogens Rhizoctonia solani and Pyricularia oryzae. Applied Biosciences, 4(3), 41. https://doi.org/10.3390/applbiosci4030041

